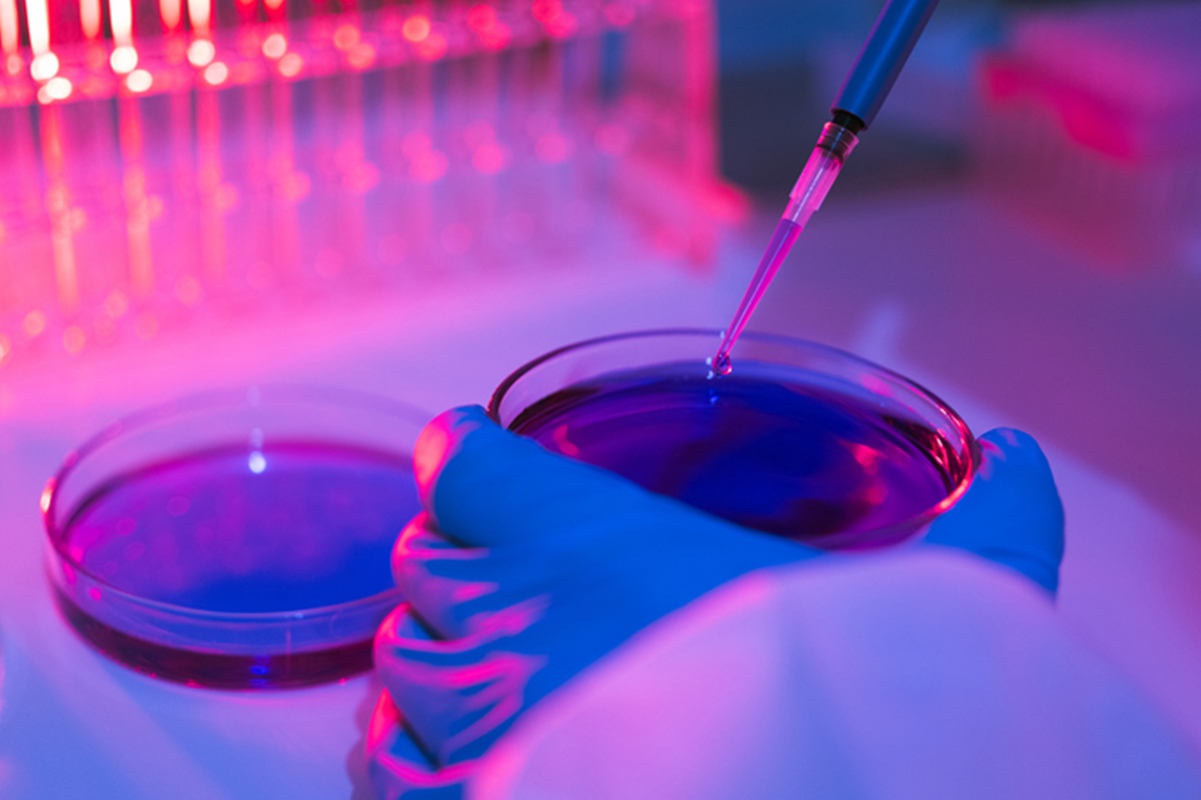

O fenômeno das pesquisas fraudulentas está em ascensão ao redor do mundo e coloca a ciência em risco, alertam especialistas. Um novo estudo revelou que extensas redes de atores mal-intencionados trabalham para publicar estudos falsos, crescendo rapidamente e atuando de forma resiliente.
As conclusões, publicadas esta semana na revista PNAS, vieram da análise de mais de 5 milhões de artigos científicos em 70 mil periódicos.
“Há grupos de editores conspirando para publicar artigos de baixa qualidade, em grande escala, escapando dos processos tradicionais de revisão por pares”, disse Reese Richardson, cientista social da Northwestern University, nos Estados Unidos, e autor principal do estudo.
A pesquisa mostra evidências de que existem redes de editores de periódicos científicos que frequentemente publicam estudos com problemas de integridade. Elas se conectam, inclusive, por meio de “intermediários” a autores de estudos fraudulentos.
Leia também
Ciência
Detectores de mentira: o que os polígrafos medem e como funcionam?
Ciência
Os 6 países com as maiores reservas de terras raras do mundo
Ciência
Estudo: inalamos cerca de 70 mil partículas de microplásticos por dia
Ciência
DNA humano esconde poder de hibernar como fazem os ursos, diz estudo
“Destruição da confiança”
Os periódicos são plataformas para que pesquisadores compartilhem suas descobertas, teorias e ideias. Existem dezenas de milhares deles, cada um com temas específicos e diferentes níveis de impacto científico.
Estudos fraudulentos publicados nos periódicos podem incluir dados fabricados, resultados não verificados, pesquisas plagiadas ou imagens manipuladas.
O fenômeno das fraudes sistemáticas passa por vários atores, incluindo as “fábricas de artigos”, que produzem estudos em larga escala em baixa qualidade ou sem a devida integridade, e os “periódicos predatórios”, que publicam estudos sem o controle esperado.
Já nos chamados “periódicos de autopromoção”, os próprios autores dos artigos são editores dos periódicos onde publicam seus estudos.
“Esse tipo de fraude destrói a confiança na ciência. Distorce análises sistemáticas e meta-análises, atrasando tratamentos e novas pesquisas”, afirma Anna Abalkina, cientista social da Universidade Livre de Berlim, que não participou do estudo.
Estima-se que até um em cada sete artigos contenha dados falsos. A inteligência artificial também alimenta a má conduta científica. “É possível mapear redes de duplicação de imagens que chegam a milhares de artigos”, prossegue Richardson.
Impacto global
Outra conclusão do estudo é que as pesquisas fraudulentas estão espalhadas pelo mundo todo e são sistemáticas, e não apenas como uma exceção fora da Europa ou dos Estados Unidos, como muitos no meio científico acreditam.
Vários casos de destaque de fraude científica já vieram à luz. Durante a pandemia de Covid-19, pesquisas fraudulentas foram usadas para fundamentar decisões políticas sobre o uso da hidroxicloroquina como tratamento.
“É angustiante ver outras pessoas cometendo fraude e enganando os outros. Mas, se você acredita que a ciência é útil e importante para a humanidade, então precisa lutar por ela”, afirma Luis Amaral, da Northwestern University, autor sênior do estudo.
Grupos de publicação científica trabalham para criar novos métodos de identificar pesquisas fraudulentas e retratá-las — ou seja, fazer uma retificação pública uma vez que são detectados problemas graves. Uma grande editora a nível internacional, a Springer Nature, por exemplo, retratou 2.923 artigos de suas publicações em 2024.
As evidências do novo estudo mostram que indivíduos cooperam para publicar artigos que já foram retratados por vários outros periódicos.
Baixa valorização da ciência
Especialistas afirmam que o problema, em última análise, está na baixa valorização da pesquisa científica, no alto grau de incerteza da academia e na elevada competitividade entre cientistas.
Empregos e financiamentos científicos dependem da produção de artigos, fazendo com que cientistas sofram com a falta de recursos e se sintam pressionados a publicar em periódicos.
Outras pesquisas citadas pelo estudo na PNAS já sugeriram que a má conduta científica está associada à percepção de um mercado injusto e à falta de oportunidades ou de treinamento.
“O aumento da desigualdade no acesso aos recursos pode estar contribuindo para o aumento da escala da fraude científica. No entanto, mesmo quando se dispõe de recursos, a pesquisa continua sendo uma atividade de alto risco — não se sabe a priori se um estudo será bem-sucedido ou não,” escreveram os pesquisadores.
Por isso, a melhor solução para combater publicações fraudulentas, segundo Richardson, é abandonar métricas quantitativas de avaliação científica, como a contagem de publicações e citações.
Siga a editoria de Saúde e Ciência no Instagram e fique por dentro de tudo sobre o assunto!
Fonte: link original